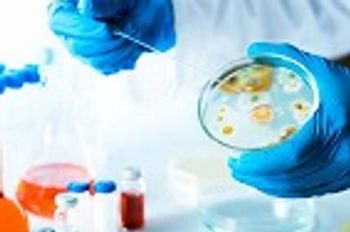

A recent report describing the development of “flesh-eating bacteria” in a Louisiana woman has the public concerned. The infection developed after the woman injured her foot, resulting in bleeding, while surf fishing in the Gulf of Mexico earlier this May.





































































































































